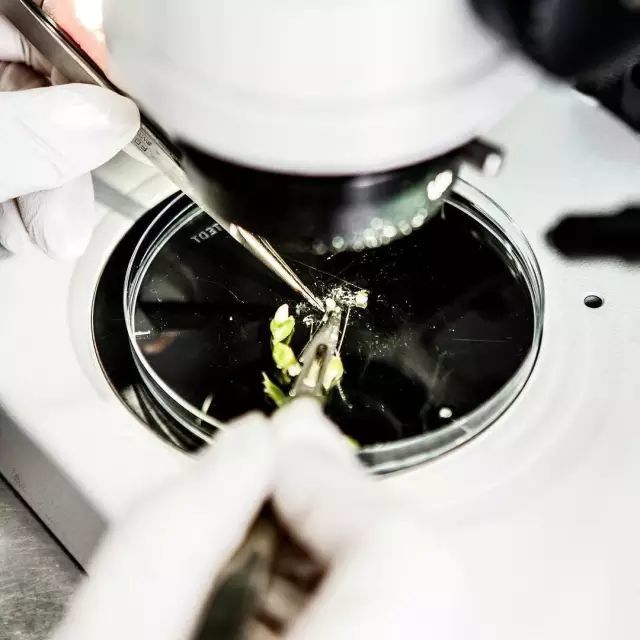
图片

韧带层抗衰(二)
应对原理:韧带滋养,增强韧带拉力
具体方法:中胚层疗法,滋润到真表皮层


EGF,中文名表皮生长因子,拿过诺贝尔奖,在医学上广泛运用。而蓓欧菲是第一个从植物中提取EGF并运用到护肤品里的牌子,也是靠着“EGF大麦sh寡肽-1”这个核心成分一炮而红的。

因为太火,跟风的EGF护肤品有不少,但说实话,恐怕都加一起,也没蓓欧菲能打。
欧美有好多明星,都是蓓欧菲的忠实用户。比如,一向挑护肤品特别有眼光的贝嫂,还有布拉德·皮特、乌玛·瑟曼。
已逝的Chanel设计总监老佛爷Karl Lagerfeld,化妆包里随身携带蓓欧菲。

EGF小魔瓶+一帖修复王
不夸张地说,这套treatment非常彪悍,拯救紊乱的水油和脆敏,足以封神

最近在北京姐妹应该有感受,冷风跟冰刀子一样,割的脸生疼!安妮最近要来不来的姨妈,激素紊乱彻底爆痘,家里还有EGF小魔瓶+修复王,一直在群里震惊感慨:
连续用了1周小魔瓶,2次的冰封王
皮肤压会了好皮状态👇
“极光”肌

只要是红,发热,风团,疹子,突然冒出来的占起的不凸起的炎症,皮肤脆到发干发痒发皱,都管用

抗衰+极速冰封修复+滋养柔嫩=一瓶搞定

bio可谓是初代贵妇抗衰届的「大魔王」,没有它救不回来的受损皮

而这底气就来自Bioeffect蓓欧菲与生俱来的高起点,它背靠的是生物医学和基因研发这块的大佬——冰岛ORF🧬科技公司
而且它的成文研发是来自于3位冰岛受诺奖的科学家启发创办

他们用地富含矿物质的纯净冰岛温泉水浇灌着130,000株生物工程,更有24小时的地热、人工照明和保温。
利用纯净生物细胞活化剂技术,将人T表皮生长因子EGF的基因片段,植入了植物,通过🧬重组工程,提取的植物EGF,有能在人源化细胞内进行作用。
作用就能够促进皮肤细胞的再生,修护受损皮肤,减少细纹,松弛皮、脆敏皮、大干皮的救星。
EGF精华非常温和,做过医美项目后,还有刷酸之后,都可以用它来修护。
甚至就连过敏的时候也能用,它可以增加皮肤厚度,建立健康的肌底屏障,实验数据可是相当惊人哦👇



当时,得亏带了EGF和冰封王,她的脸灼烧感半个多小时还不退,就赶紧用冷水洗了下脸。




这套treatment非常彪悍,很简单,就是洗完脸,先涂EGF,薄涂厚涂都行,看你皮肤的状态,涂上以后,立马敷一帖修复王。
冷知识科普了一下啊脆敏皮的人
老得更快、皮肤更松

而脆敏皮最常见的发作信号:灼热、红血丝、疹子、红团、干燥起皮、油脂异常......

暴风哭泣,再次提醒,脆敏皮可得注意皮肤的「健康度」,真的红了赶紧用EGF镇压下去,可得搞清楚脆敏皮K老的核心基盘

老业主应该都EGF小魔瓶都很熟悉了,真的能4滴出奇迹
尽管是在北京刀子风的席卷下,也完全hold住
敏感肌:好皮定心丸
干皮:24小时深润,滋养皮肤,紧致抗衰
油敏皮:加速抗细胞炎性,手贱星人不用担心留疤
赖人党:一瓶多效,洗脸单用一个小魔瓶就足够了,第二天惊艳细嫩白
医美爱好者:有皮损的人,都可以后续叠加,修复力很强
